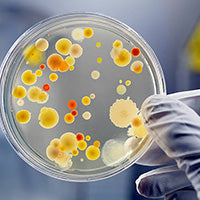

i-biosafe Hava Temizleme Cihazlarının Profesyonelliği ile
Daha Güvenli Yaşam Alanları
Hava kaynaklı partiküllerin, hızlı ve etkin mobil HEPA filtrasyonu

Hangi i-biosafe modelini seçmeliyim?
- Cihazda kullanılan filtre tipleri,
- Hava akışkanlık özellikleri,
- Cihazın tasarımı,
- Gerçek partikül düşürme etkinliğini zamana bağlı olarak gösteren CADR değeri,
- Kullanılacak ortamın büyüklüğü
gibi kriterler uygun cihaz seçimini belirler. Dolayısıyla öncelikle kullanıcı ihtiyaçlarının doğru şekilde belirlenerek cihazın sahip olması istenen kriterlerin de bu doğrultuda seçilmesi gerekiyor.

Kullanım Alanları
- Küçük odalardaki uygulamalar için hijyenik hava kaynaklı partikül temizliği
- Nötropenik veya bağışıklığı baskılanmış hasta odalarında parçacık ve mikroorganizmaların uzaklaştırılması
- Kalabalık ortamlarda oda içinde hava yolu ile bulaşan patojenlerin ve kontaminantların seyreltilmesi
- Poliklinikler, laboratuvarlar, hastane içi küçük izolasyon ve müdahale odaları
- Özellikle ev ve ofisler için pratik taze ve HEPA filtre edilmiş temiz hava temini
Görülemeyen hava ve partiküllerin yönetimi

Alerjenler

Evcil Hayvan Tüyleri

Sigara Dumanı
Mikroorganizmalar

Toz

Polenler

Hijyenik Filtre Verimlilikleri
Bir filtreye HEPA (Yüksek Verimli Partikül Hava Filtresi) denebilmesi için H sınıfı filtre olmalıdır. EPA filtrelerin verimi HEPA filtreye göre daha düşüktür.

HEPA Filtre Güvenceli
Filtreler görsel olarak ayırt edilemez. Bu nedenle hava temizleme cihazında takılı olan ana filtrenin uluslararası standartlara sahip filtre üreticisinden alınmış sertifikası bulunması önemlidir.

i-biosafe
Hijyenik ve Güvenli Havanın Kalbi

Doğru Hava Akış Teknolojisi
Profesyonel temizodalarda yapılan testlerden alınan sonuçlar; en iyi partikül temizleme performansına ait hava akım tekniğinin tavandan tabana doğru olan hava yönlendirme ile tabana yakın şekilde toz ve partiküllerin cihaz tarafından emilmesidir.

Sağlam ve Kompakt Tasarım
- Kanıtlanmış Hava Temizleme Oranı (CADR)
- UV-C lamba ile filtre dezenfeksiyonu
- Rehberlerce Tavsiye Edilen Saatlik Hava Değişim (ACH) Uygunluğu
- Hijyenik ve Etkin Hava Kaynaklı Partikül Sayısının Düşürülmesi
- Etkin, Ekonomik, Kompakt ve Pratik Oda Basınçlandırma Entegreli Taşınabilir Hava Temizleme Cihazı

Sürekli Ölçüm
Partikül ve uçucu organik bileşen(VOCs) sensörleri havayı sürekli olarak izler ve renk kodlu bir gösterge ile ortamın hava kalitesini belirtir.

Oda Basınçlandırma
i-biosafe hava temizleme cihazları üzerinden pozitif/negatif oda basınçlandırma imkânı yaratılmaktadır. Basit bağlantı aparatları ile pencere veya duvarda açılan ventilasyon kanalı ile cihaz arasında bağlantı oluşturularak ek bir cihaz gerekmeden basınçlandırma yapılmaktadır. Odanın sızıntı durumuna göre veya istenen miktarda hava alışverişi ayarlanarak filtrelenmiş hava resirkülasyonu ve kontrollü oda basınçlandırılması i-biosafe cihazlarında otomatik olarak gerçekleştirilmektedir.
*Görsel negatif basınçlandırmaya aittir.
*Oda basınçlandırma talepleriniz için lütfen iletişime geçiniz.
PRO SERİSİ; AC-1500 MODEL HAVA TEMİZLEME CİHAZI
Sağlık Bakanlığı’nca Etkinliği Onaylanmış “Aktif Madde İçermeyen Biyosidal Ürün” Belgeli
Daha detaylı bilgi için lütfen iletişime geçiniz...